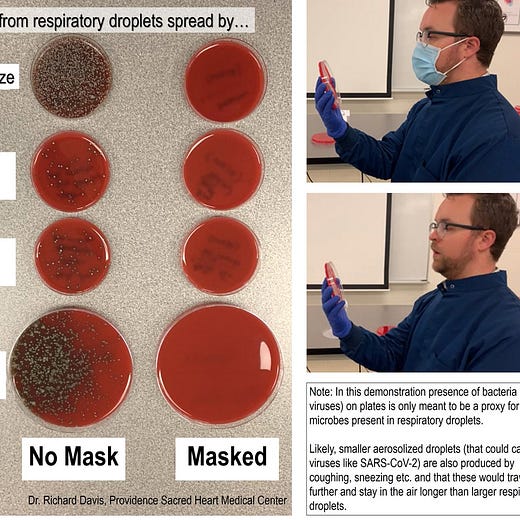
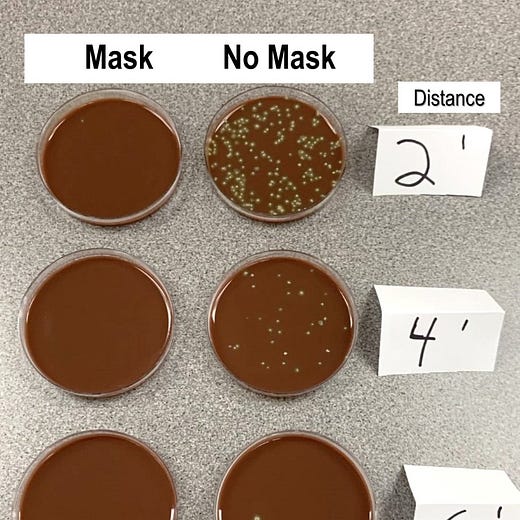

4: Tobias Lütke, Giant Swords, and Bats Flying into Parked F117A Stealth Planes
“stop treating life like a checklist to finish”
L’avenir n’est plus ce qu’il était. -Paul Valéry
(My translation: The future is not what it used to be.)
I decided to attempt putting titles on these things. Because there’s typically not one theme per letter, it’s almost impossible to have a unified title that makes sense, but I’ll do my best to give a sample across sections. I went back and titled the first 3 letters. If you haven’t seen them and would like a look, you can find them in the archive.
Investing & Business
-That Escalated Quickly (2016 -> 2020)
Context below, for those who don’t know of Slack’s 2016 full-page advertisement in the NYT giving Microsoft “advice” on its competing product, Teams.

-How Wise is Tobias Lütke?
-Intel’s Problems: Not Just About Position, but Rate of Change
It’s certainly not a good sign that über-engineer Jim Keller recently joined, and then left, Intel.
Just for fun, the market caps of Intel, Nvidia, and AMD:

-Businesses Going from Using Software to Being Software
In Edition 2, I shared some excerpts from a podcast interview with Eric Vishria on Invest Like the Best about software. One of them was:
Eric Vishria: Businesses have historically used software. But now, businesses are basically becoming encoded in software. What you need is not a person necessarily using software, but you have software using other software… It’s not interacting through a user interface, it’s interacting with other software through an API.
A good illustration of what this looks like can be found in this 2019 piece by Confluent CEO Jay Kreps:

The purpose of an application, in this emerging world, is much less likely to be serving a UI to aid a human in carrying out the activity of the business, and far more likely to be triggering actions or reacting to other pieces of software to carry out the business directly (Source)
-“We will never buy desktops ever again. It will never happen in our shop.”
Quote from George Kurtz, the CEO of Crowdstrike, a cloud security company, from a presentation at a conference on June 10, 2020:
We spoke to a CIO who basically said, "Hey, I had a 2-year digital transformation road map that I executed one night in March.”
"Hey, this is not going to happen again, right?" We're going to be prepared. I mean, I talked to one CIO of a huge company and [he] said, "We will never buy desktop ever again. It will never happen in our shop." And that's a broad statement, right?
Because they had to ship everybody home, and they needed laptops, right? And part of that sort of thinking of this will not happen again is, okay, we're going to move a bunch of stuff to the cloud. We were going to do that, but we're going to do it even faster because we don't know what's going to happen. And as they accelerate those road maps, you're not going to move anything to the cloud unless you have the check box for security. It's just not going to happen.
[…] that became a blocker if you don't have security. So they have to check off the security, and then they can migrate over a period of time. So it's almost a foundational piece, the shelter, as I call it, in the corporate hierarchy of needs. You have to have [security] before you can go up and migrate those applications.
I thought this part of the conversation about how many modules they sell on the same endpoint agent was interesting, it reminded me of how the tower companies really start making money when they have multiple tenants on the same tower:
we're replacing a lot of agents in the overall environment, and I think that's probably an area that's under-appreciated, just how much pain is involved for it. Large and small companies with all these agents they have, collecting the same information multiple times and bogging down the system [...] Many times, we replace up to 4, 5, 6 different agents out there. [...]
As we add more modules, every single module after the first line becomes virtually pure profit.
I think they last reported that they had mid-50% of their customers on 4-or-more modules.
-Great Interview with Dennis Hong of ShawSpring Partners
Topics covered: How Dennis got into investing, working with David Swensen at Yale, how small funds can structure themselves to have an edge, Altimeter, dropping out of HBS, founding Shawspring in 2016, two optimization problems when launching a fund (AUM & returns), concentration in 5-10 stocks, how to maximize return-on-time-spent when investing, learning from mistakes, how to identify high-quality companies, what is ecosystem-control, aggregation businesses, winner-takes-all or most, vertical integration, capital intensity can be good, the CAC benefits of cognitive referents, evaluating managers, Carvana, low portfolio turnover (1-2 stocks per year), evolution of cash position & market-timing, Tencent, aiming for 30% gross returns, KPIs for each investment, portfolio construction, starter position size (10%), CPG companies in China, IAC, Match Group, Tinder, “I’m not even sure Amazon is that good at e-commerce”, “It’s day 1 for everybody, every day in China”, COVID19 impact, finding businesses that will be improved by crisis.
The video is 1h30 long, but the conversational pace means it’s easy to follow at 2x speed (45 minutes). You can follow Dennis on Twitter, or learn more from Shawspring’s website.
-What to Do When You’re Stuck as an Investor
-Beware of Diversity Breakdowns…
Markets are typically pretty efficient because of the ‘wisdom of crowds’ effect, but for this effect to work well, you need a high diversity of agents, with different strengths and weaknesses, different biases, different perspectives, etc. When everybody thinks the same, it suddenly stops mattering that you have many people, since they more-or-less act as one, and crowd to the same side of the boat at the same time. That’s a ‘diversity breakdown’.
Averaging can eliminate random errors that affect each person's answer in a different way, but not systematic errors that affect the opinions of the entire crowd in the same away. (Source)
-Liz Hall Podcast
Short podcast interview with my friend Liz by Steve Hely (38 mins, but only 19 mins at 2x, so you’ve definitely got time while loading the dishwasher).
Always interesting perspectives and original thought patterns.
Science & Technology
-This is What an Empty Boeing 787 Looks Like

To get an idea of scale, look at the side-windows. (Source, via Massimo.)
-U2 and F117A Spy Plane Anecdotes


This is from the book ‘Skunk Works: A Personal Memoir of My Years at Lockheed’ by Ben Rich. Great book, highly recommended.
-More & Faster Testing, Please
-The Bus Ticket Theory of Genius
Great essay by Paul Graham that I somehow hadn’t seen until Mostly Borrowed Ideas pointed it out to me:
When you look at the lives of people who've done great work, you see a consistent pattern. They often begin with a bus ticket collector's obsessive interest in something that would have seemed pointless to most of their contemporaries. One of the most striking features of Darwin's book about his voyage on the Beagle is the sheer depth of his interest in natural history. His curiosity seems infinite. Ditto for Ramanujan, sitting by the hour working out on his slate what happens to series.
It's a mistake to think they were "laying the groundwork" for the discoveries they made later. There's too much intention in that metaphor. Like bus ticket collectors, they were doing it because they liked it. […]An obsessive interest in a topic is both a proxy for ability and a substitute for determination. Unless you have sufficient mathematical aptitude, you won't find series interesting. And when you're obsessively interested in something, you don't need as much determination: you don't need to push yourself as hard when curiosity is pulling you. […]
Interest is much more unevenly distributed than ability. If natural ability is all you need to do great work, and natural ability is evenly distributed, you have to invent elaborate theories to explain the skewed distributions we see among those who actually do great work in various fields. But it may be that much of the skew has a simpler explanation: different people are interested in different things.
Worth reading the whole thing, and maybe also Richard Hamming’s ‘You and Your Research’ if you’re in the mood to think about how to steer your work life in productive directions.
-It’s not Because the Village Idiot says the Sky is Blue that it Isn’t
Doing the opposite of what others are doing can be just as unthinking as blindly following what others are doing. The mirror image of something is still fundamentally tied to that thing.
It’s too bad the investing community has settled on the word ‘contrarian’ to describe what really should be ‘independent thinking’, because I think some people end up being misled by the label.
-Replication of Mask Experiment
The guys at AsapSCIENCE replicated this experiment from microbiologist Richard Davis on the ability of simple masks (surgical or homemade cloth, in this case) to reduce or stop the spread of respiratory secretions (he addresses that these cultures are bacteria and not viruses, but the point is that both are carried by the same droplets, so blocking them will block a lot of both):
-¯\_(ツ)_/¯
The Arts
-Sverd i fjell, Norway

The monument was created by sculptor Fritz Røed from Bryne and was unveiled by King Olav V of Norway in 1983. The three bronze swords stand 10 metres (33 ft) tall and are planted into the rock of a small hill next to the fjord. They commemorate the historic Battle of Hafrsfjord which by tradition took place there in the year 872, when King Harald Fairhair gathered all of Norway under one crown. The largest sword represents the victorious Harald, and the two smaller swords represent the defeated petty kings. The monument also represents peace, since the swords are planted into solid rock, so they may never be removed. (Source)

-Underrated Movie Recommendation: ‘The Death of Stalin’ (2017)

One of my favorites of the past few years. If you enjoy black comedy and satire, and want to see Steve Buschemi play Nikita Khrushchev, you’ll enjoy this one. Great writing and directing by Armando Iannucci.
It sometimes feels like a really good play, and sometimes lets you peak at a much larger world. It took the wise decision of mocking the power-hungry maniacs, but of taking very seriously the plight of everybody else.
The actor who plays Lavrenti Beria is scary good. I can’t see him as anything else but the real Beria and totally forget he’s an actor.
My rating: A
-Leaving You With These Important Thoughts